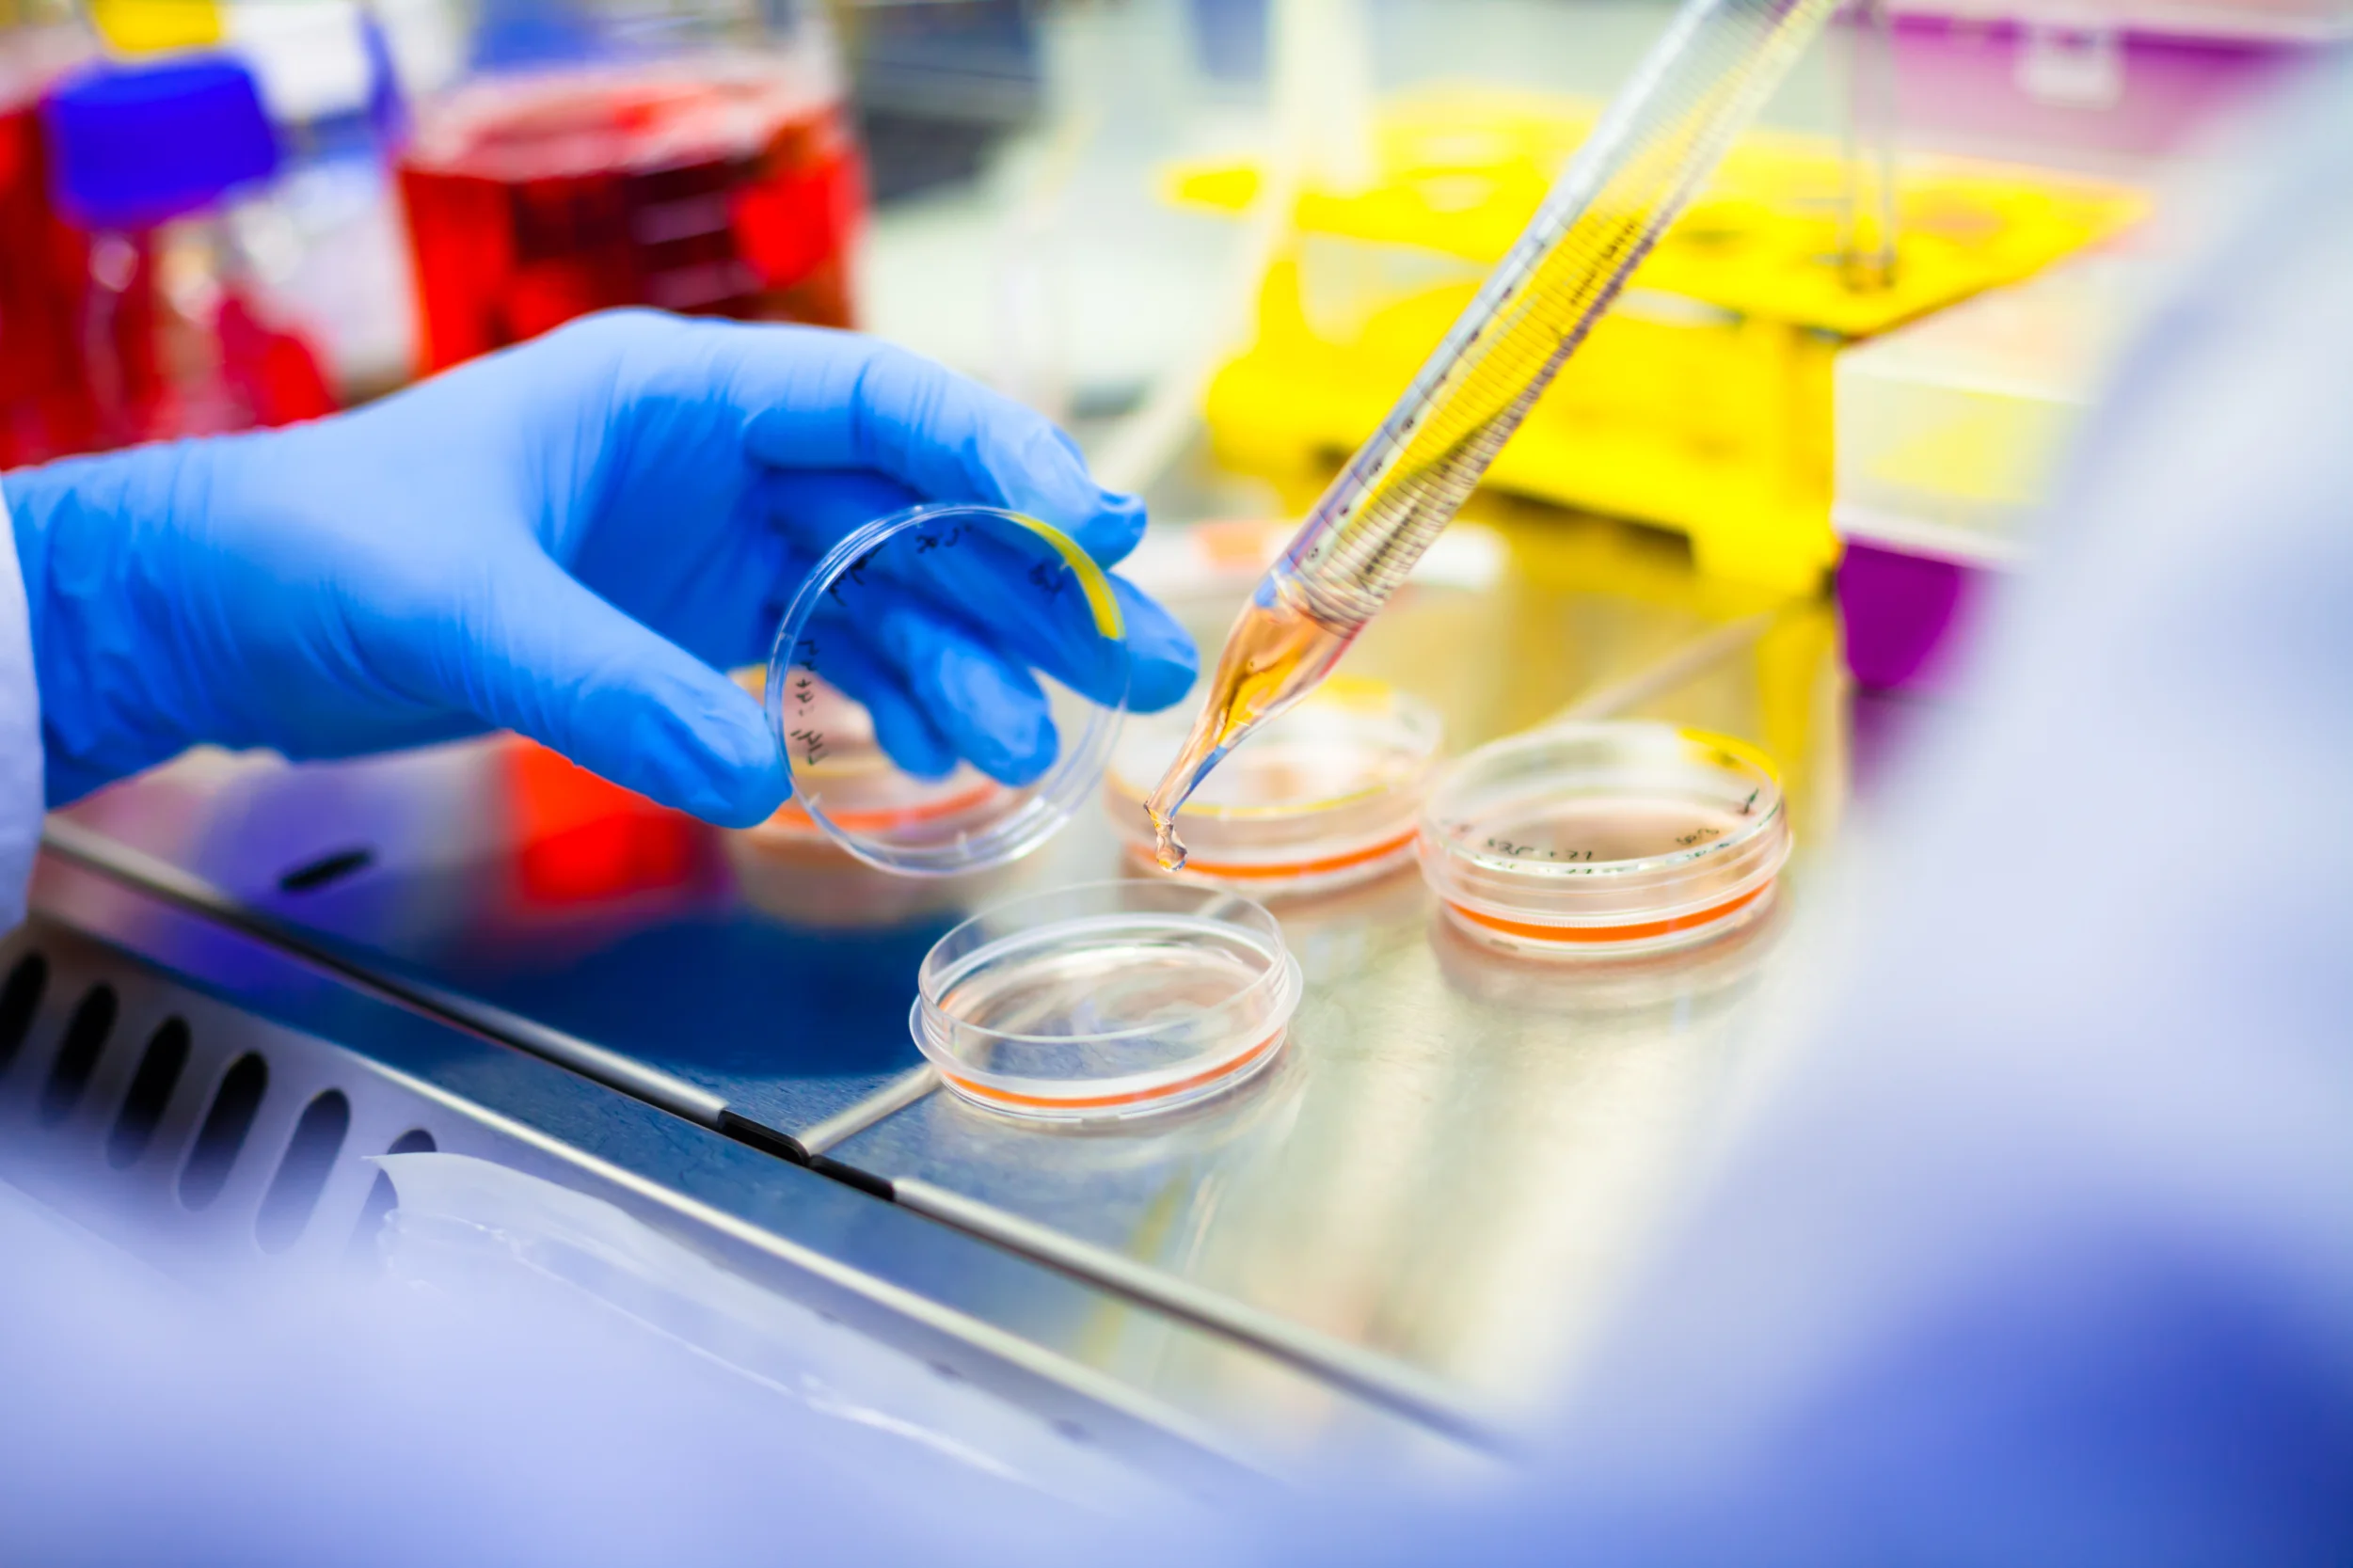

Lead optimized compound was presented in American Association of Cancer Research (AACR) Annual Meeting in Orlando in 2023. Researchers have identified a novel and potent TACC3 protein-protein interaction inhibitor, aimed at treating highly aggressive cancers. This inhibitor, developed through a collaboration between A2A Pharmaceuticals and OncoCube Therapeutics, has demonstrated significant efficacy in preclinical models by inhibiting tumor growth in various cancer types. The study highlights the potential of this new inhibitor to provide effective treatment options for cancers with high unmet medical needs.




